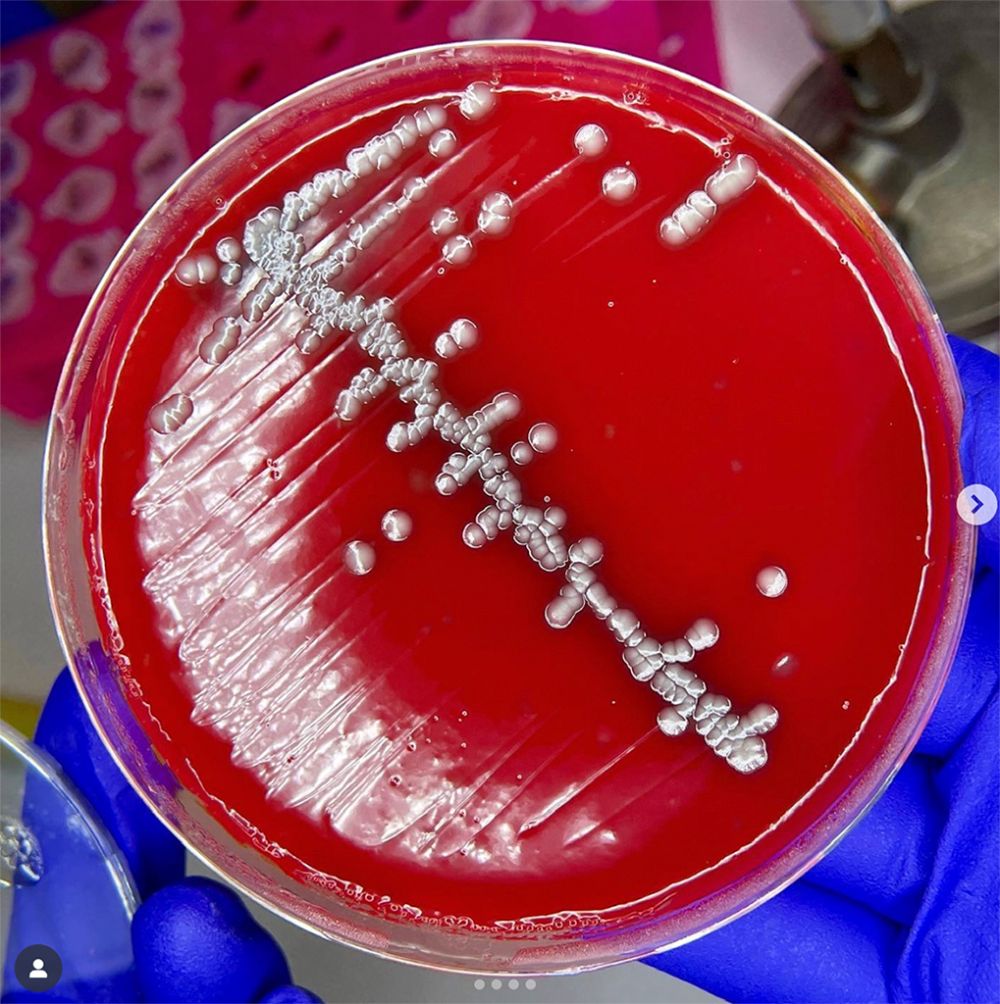
perros

Un equipo de la Facultad de Ciencias Veterinarias y Pecuarias (FAVET) de la Universidad de Chile descubrió que los perros domésticos sanos pueden portar bacterias resistentes a los antibióticos usados en medicina humana, y que estas bacterias pueden circular entre los animales y las personas con las que conviven.
El estudio -publicado en la revista Animals- se titula “The Risk Factors Associated with the Carriage to Critical Antimicrobial-Resistant Escherichia coli in Healthy Household Dogs: A One Health Perspective”, y fue desarrollado por Carlos Alejandro Zelaya, Gabriel Arriagada, Rosario Medina, Beatriz Escobar, Fernando Sánchez, Nicolás Galarce y Lisette Lapierre, académica de FAVET y autora corresponsal del trabajo, con financiamiento del proyecto Fondecyt N°1210692.
“Casi uno de cada cinco perros analizados portaba cepas de Escherichia coli resistentes a antibióticos de uso crítico en salud humana”, explica la profesora Lapierre, académica del Departamento de Medicina Preventiva Animal de FAVET.
“Estos microorganismos pueden transmitirse desde los animales a las personas, pero también a la inversa: compartimos la misma microbiota con nuestras mascotas, lo que significa que también nosotros podemos traspasarles bacterias resistentes a ellos”, agrega la investigadora.
Riesgos invisibles en clínicas y criaderos
La investigación analizó muestras fecales de 263 perros sanos de distintas comunas de la Región Metropolitana y estableció una serie de factores de riesgo y de protección. Entre los más relevantes, los perros hospitalizados en clínicas veterinarias presentaron cuatro veces más probabilidades de portar bacterias resistentes, mientras que los perros comprados en tiendas o criaderos tuvieron seis veces más riesgo que los adoptados.
“En algunos criaderos se administran antibióticos preventivos a cachorros que ni siquiera están enfermos, solo para asegurar su venta. Pero eso puede seleccionar bacterias resistentes que luego pueden llegar al hogar y transmitirse a las personas”, advierte Lapierre.
El hallazgo ya ha despertado interés en el Ministerio de Salud, que busca integrar evidencia científica en futuras regulaciones sobre el uso de antimicrobianos en animales de compañía y en las medidas de bioseguridad de clínicas y criaderos.
Factores protectores: educación y contacto social
El equipo también detectó factores protectores inesperados. Los perros que convivían con personas del área de la salud -como médicos, enfermeros o veterinarios- presentaron menor probabilidad de portar bacterias resistentes, probablemente por mejores hábitos de higiene y un uso más racional de los antibióticos.
De forma contraintuitiva, los perros que tenían contacto ocasional con otros animales -por ejemplo, en parques o paseos- también mostraron menor resistencia bacteriana. “Creemos que la exposición a distintas bacterias puede diversificar la microbiota y reducir la presencia de cepas resistentes, aunque esto requiere más investigación”, comenta la académica.
Una salud, un solo desafío
La profesora Lapierre destaca que la resistencia a los antimicrobianos es uno de los mayores desafíos sanitarios del siglo XXI, y que su prevención debe abordarse bajo el enfoque Una Salud (One Health), que considera la salud humana, animal y ambiental como un sistema interdependiente.
“Si seguimos usando antibióticos sin diagnóstico ni control, llegará un momento en que no tendremos medicamentos eficaces ni para humanos ni para animales”, advierte. “Por eso, más que alarmar, queremos educar: entender que nuestras mascotas son parte de la familia y que cuidarlas también implica usar los antibióticos con responsabilidad”.
El estudio concluye que una tenencia responsable, junto con una regulación más estricta del uso de antimicrobianos en la práctica veterinaria, podría reducir significativamente la propagación de bacterias resistentes.
“No se trata de tener miedo a los animales, sino de asumir que vivimos conectados -dice la profesora Lapierre-. La salud de ellos es también la nuestra”.